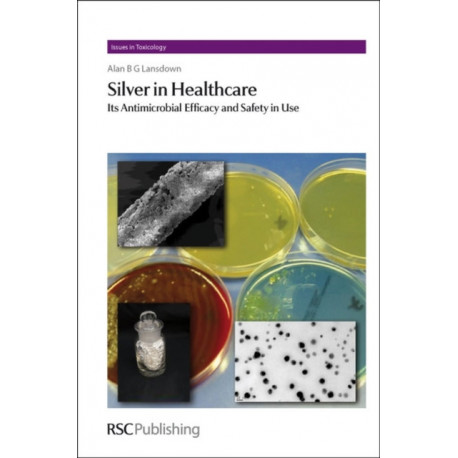

Kurv
Vare
varer
(tom)
Ingen varer
Fastlægges senere
Forsendelse
0,- kr
I alt
Silver in Healthcare: Its Antimicrobial Efficacy and Safety in Use
(Bog, Hardback, Engelsk)
Forlag:
Royal Society of Chemistry
- Type: Bog
- Format: Hardback
-
Sprog:
Engelsk

- ISBN-13: 9781849730068
- Se flere detaljer ▼
Bemærk: Kan ikke leveres før jul.
Beskrivelse
A comprehensive account of the history of silver in medicine, its clinical benefits and advantages as a broad spectrum antimicrobial agent.
Læsernes anmeldelser (0)
Alle detaljer
| Forlag | Royal Society of Chemistry |
| Forfatter | Alan B. G. (Imperial College London Lansdown |
| Type | Bog |
| Format | Hardback |
| Sprog | Engelsk |
| Udgivelsesdato | 07-05-2010 |
| Første udgivelsesår | 2010 |
| Serie | Issues in Toxicology |
| Illustrationer | No |
| Originalsprog | United Kingdom |
| Sideantal | 280 |
| Indbinding | Hardback |
| Forlag | Royal Society of Chemistry |
| Serieredaktør | Diana Anderson |
| Sideoplysninger | 280 pages |
| Mål | 164 x 241 x 21 |
| ISBN-13 / EAN-13 | 9781849730068 |

